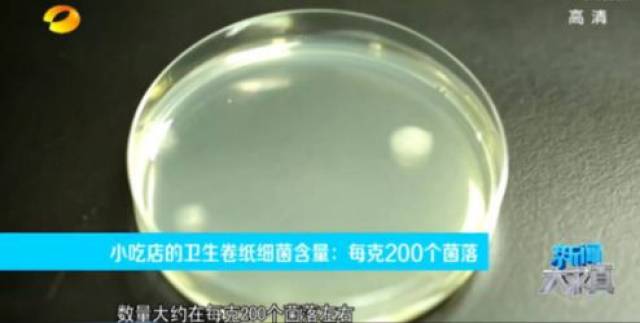
拼多多“黑心”简装纸尿裤令人发指,那简装纸巾就“卫生”吗?

记者查阅了该平台上销售量比较大的纸巾、婴儿纸尿裤分别存在产品信息不明确、无法提供合格证以及傍名牌等现象。

纸巾
作为拼多多“三宝”之一
正以史无前例的速度,成为当红爆款
……



在拼多多上的纸可以说是论斤卖的,
不到9块就能买到 5.5 斤。
真正的四舍五入不要钱,免费买纸用
但记者发现,进入商家页面后,发现商家在商品详情中未标明纸巾的等级。
记者询问客服后,客服称:该产品等级为合格品。
据悉,根据国家标准GB/T 20808-2011纸巾与GB/T 20810-2006卫生纸(含卫生纸原纸)发布的相关规定,纸巾按照产品等级从高到低依次划分为优等品、一等品和合格品三个等级。它们的柔软度、吸水性、韧性都不同,优等品最好,一等品次之,合格品最差。合格品的很多项指标连一等品的一半都达不到,价格自然便宜一些。
一位消费者坦言,拼多多买的纸,她通常仅用来上厕所。

然而,从黑心纸尿裤的出炉过程看,拼多多的责任不能推脱。正是拼多多为这些黑心纸尿裤提供了遍及全国的销售渠道,让这些黑工厂做大做强。
此外,拼多多虽然发表声明,称在整个行业产业状况明晰之前,将先行在整个电商行业全面下架散装纸尿裤。但简装纸巾不仅仍在拼多多上销售,在其他电商平台上也仍有售。
当然,只从黑心纸尿裤事件,我们很难判断这些在拼多多销量火爆的纸巾究竟产自哪里,是否为合格品,是否也同样是黑工厂生产的。但我们很明确一点:
凡是包装上无“生产日期”“生产厂家”等信息的三无产品,消费者应该谨慎使用。
其实,简装纸巾质量问题引发讨论已不是第一次。早在2015年,法制晚报就披露过一款某品牌餐巾纸质量严重不合格。
生产厂家不仅使用废弃原料,而且加工环节卫生条件极差,到了触目惊的程度。

此外,记者还了解到,一些不良生产商违规使用回收废纸作为原料,然后添加各种漂白粉、漂液和增白剂让纸巾看起来更洁白;还有的造纸厂为了降低成本,还大量添加工业滑石粉。
生产环境令人堪忧,充满污垢,毫无保障。

这里说的废旧原料主要有书本、报纸、药品包装盒等,有的甚至已经发霉。

除了原料来路不明之外,检测人员还指出,检测发现有5批次的可培养细菌菌落数超标。其中,最差样品超过国家卫生指标标准4倍以上。
而细菌菌落总数不合格,属于“严重不合格”。换言之就是不卫生。

不仅如此,合格品简装纸巾也未必“卫生”
记者在其他知名电商平台发现如维达、清风、心相印等相关品牌售卖等级为优等品的纸巾,8包最少需要15.9元(不加邮费)。
而合格品的简装纸巾未必“卫生”。原来,除了劣质纸巾本身不合格带来的危害,有时候因检测标准不同,就算是合格的简装纸巾,也可能对健康有所伤害。
2015年,某期电视节目对人们生活中的常见合格品简装纸巾进行了质量抽检。调查发现,小吃店的纸巾纸菌落数量最高,每克大约有200个菌落左右。
如此一来,合格品简装纸巾有没有“卫生”的作用?我们同样很难判断。

纸巾是生活中必不可少的用品之一,但长期使用散装三无产品、劣质的简装纸巾,在无形中对于我们身体健康造成巨大危害。
博卫小编建议:消费者们在选购产品时尽量选择大型企业的大品牌。选购生活用纸产品时,应选购包装完好的产品,避免因包装破损导致微生物污染。此外,应当心太白的纸巾有可能添加有荧光增白剂等有毒有害物质。不要贪一时便宜,给家人和自己的健康带来隐患!